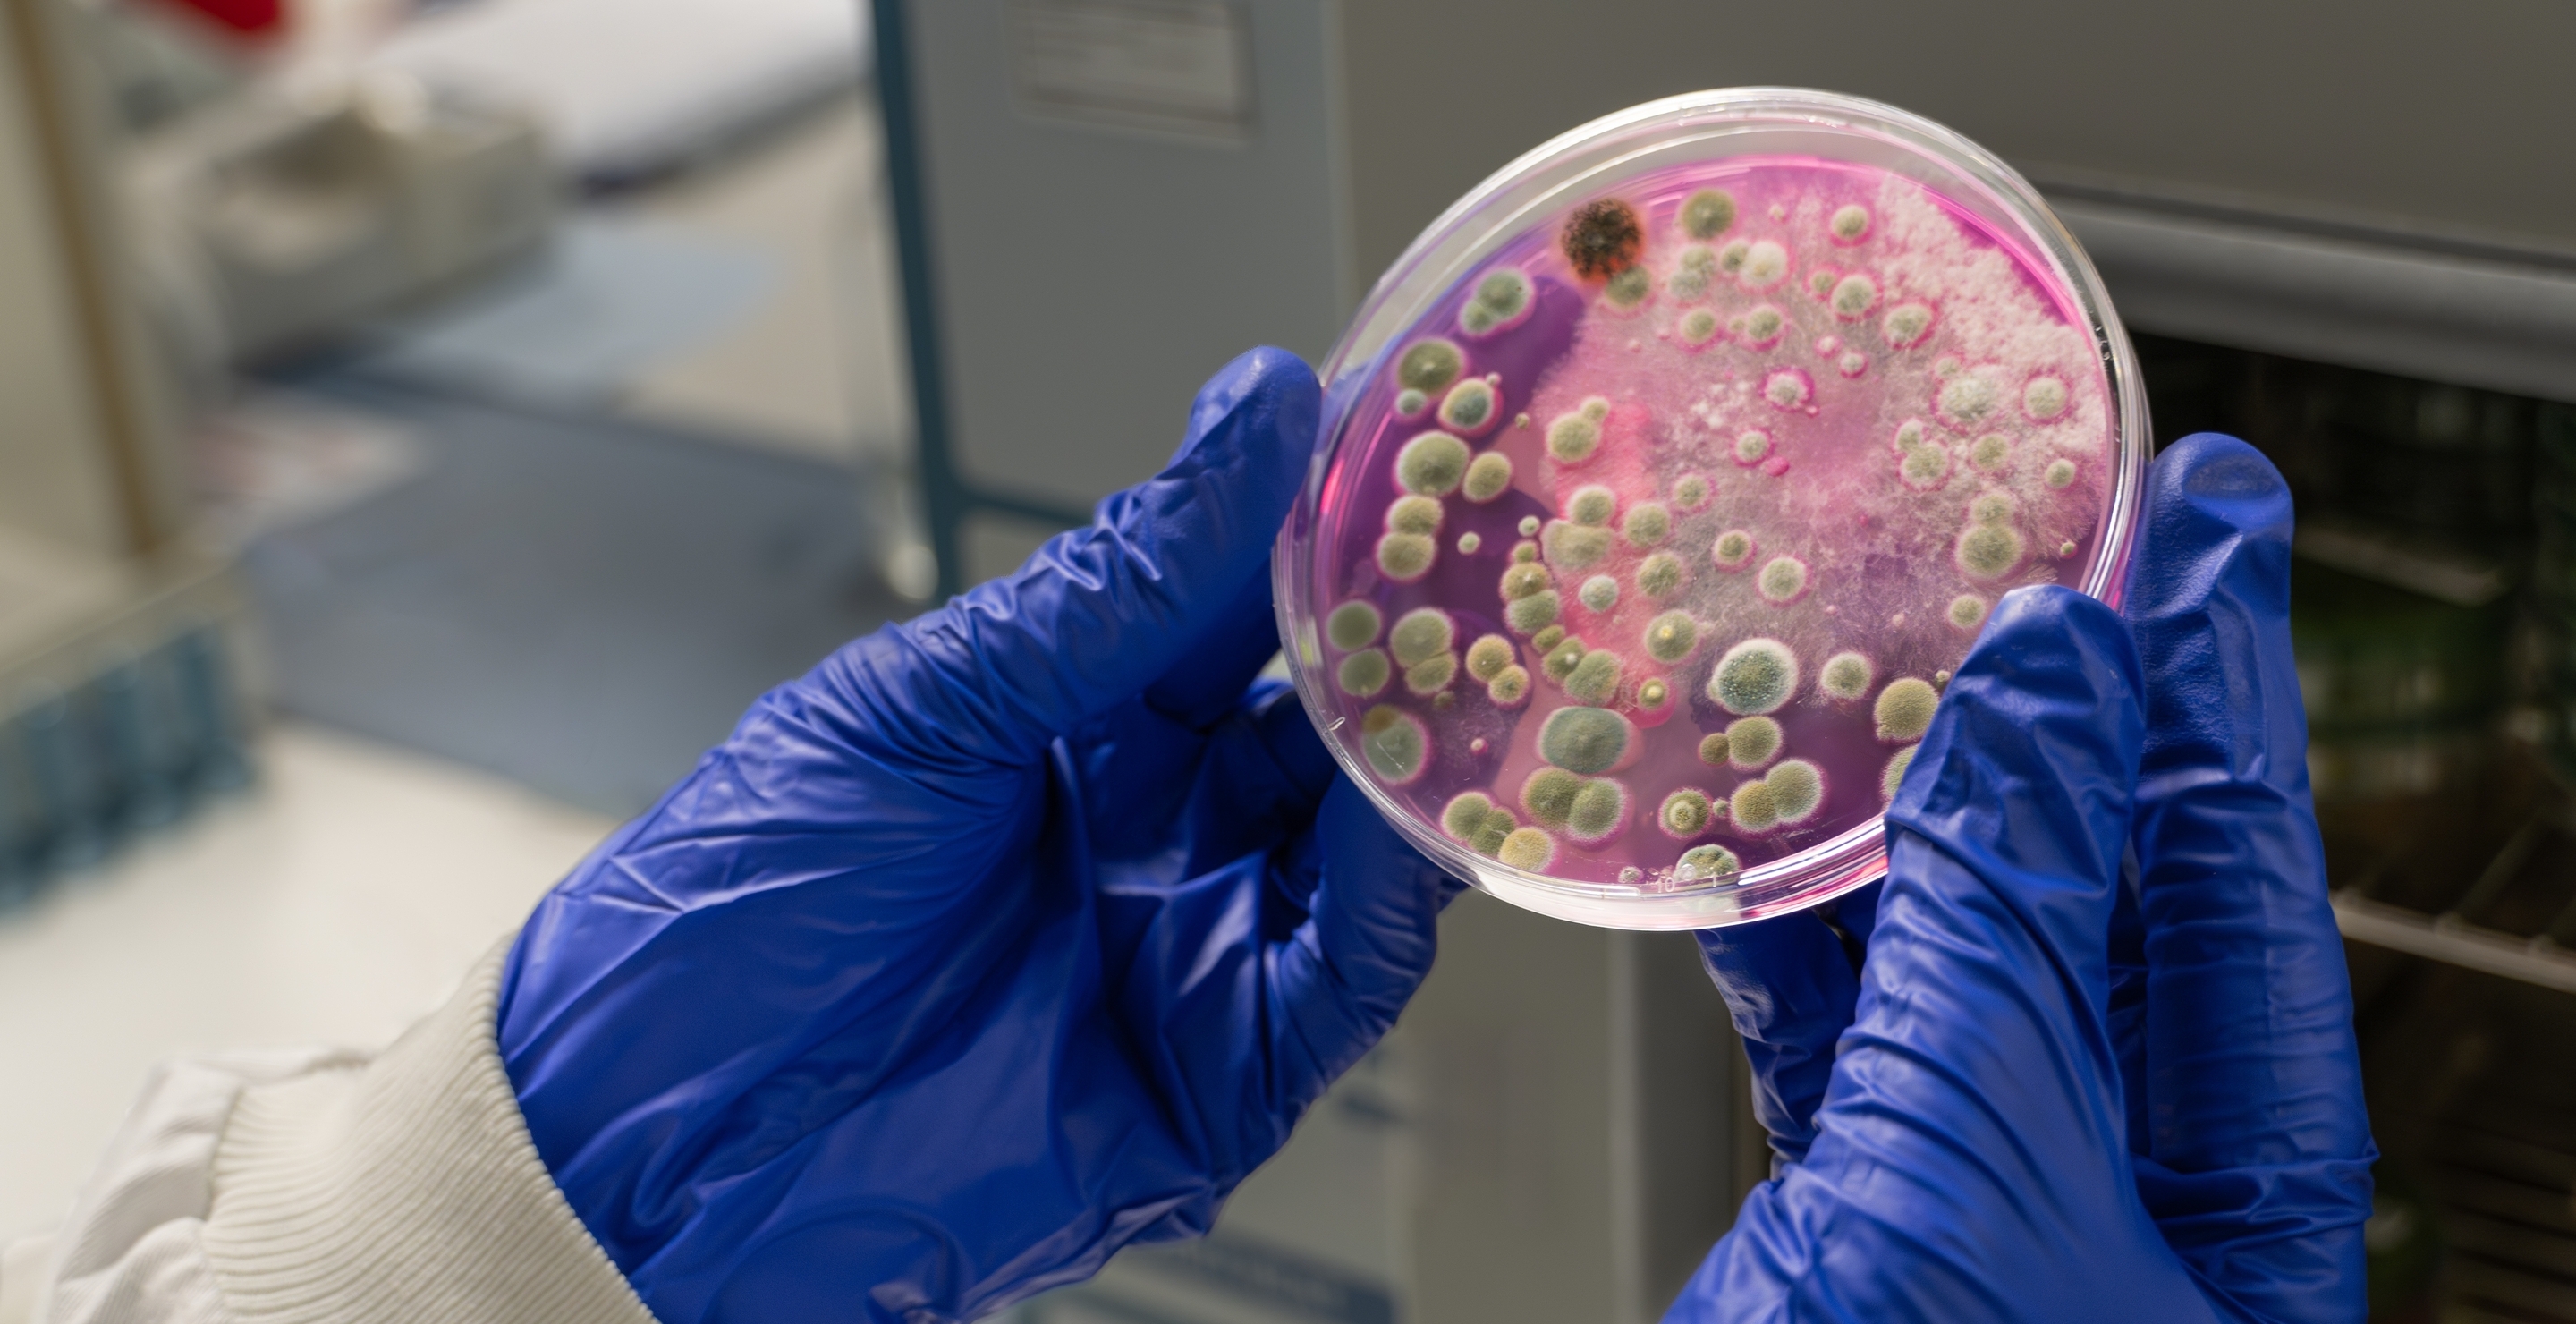

It seems like the US can’t get a break from Dickensian infections as a deadly fungus finds its way into people’s lungs.
Due to numerous environmental changes, a fungus known as Aspergillus fumigatus is on the rise, and it is not a nice thing to be involved with. The fungal infection gets into the body through microscopic spores and eats the lungs. In some cases, it can develop and move to other major organs, destroying them too.
The fungus causes a lung infection known as aspergillosis. This is especially dangerous to the vulnerable, such as people with HIV, asthma, or cancer. In some cases, it can cause organ failure and death.
The spores themselves are incredibly hard to detect, and people could be inhaling the fungus into their lungs without knowing. They thrive in hot, humid environments and are particularly resistant to drugs.
Lung-Eating Fungus On The Rise
There have been several contributing factors to the rise in the fungus that attacks the lungs. In particular, the increase in global temperatures is making the south of the US a breeding hotspot. The fungus can survive high temperatures, even being found above 120f in compost heaps.
A study by the University of Manchester predicted that with our current fossil fuel use, the fungus will expand by 75% by 2100. This will turn the southern US into a hotspot for infection cases.
The fungus has also become remarkably resistant to drugs through the overuse of pesticides. The same drug to treat fungal infections is also used in agriculture. This allows the airborne fungus to resist the effects, making it much harder to treat.
People who may be vulnerable to lung infections brought on by the fungal spores are advised to reduce their exposure. It is suggested that they stay away from things like gardening, soil, and especially dank, mouldy environments.
When in these places, including dusty spaces, it’s suggested they wear a mask to minimize the chances of inhaling the spores. Despite measures being taken, the rise of recorded levels of the lung-eating fungus is worrying experts as it spreads across the southern US.